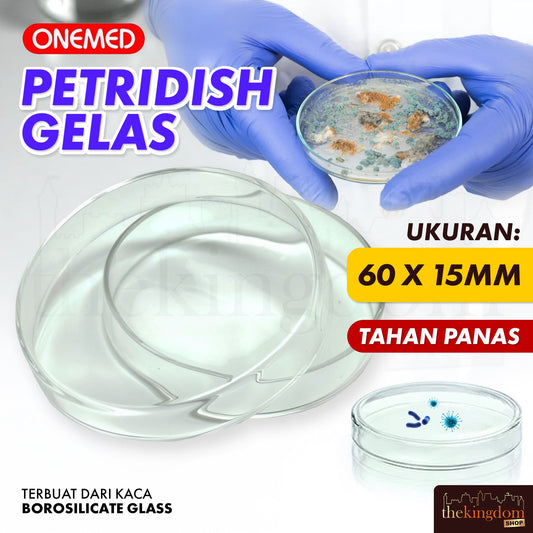
Onemed Petridish Glass

Spare Parts: Medical Equipment
Filter
Price
Product Recommendations
Sort by
- Featured
- Most relevant
- Best selling
- Alphabetically, A-Z
- Alphabetically, Z-A
- Price, low to high
- Price, high to low
- Date, old to new
- Date, new to old
There are 42 results in total
Best selling
- Featured
- Most relevant
- Best selling
- Alphabetically, A-Z
- Alphabetically, Z-A
- Price, low to high
- Price, high to low
- Date, old to new
- Date, new to old
Onemed Mediflex
Regular price
Rp 9.500
GEA FS 809 B Wheelchair with Racing Rims FS809 Wheelchair
Regular price
Rp 1.450.000
Sale price
Rp 1.900.000
Onehealth OH01J Stadiometer
Regular price
Rp 2.200.000
Sale price
Rp 3.000.000
Onehealth OHJ05 Stadiometer
Regular price
Rp 750.000
Sale price
Rp 900.000
GEA 7F-10 Oxygen Concentrator
Regular price
Rp 23.000.000
Sale price
Rp 26.000.000
GEA 7F-8 Oxygen Concentrator
Regular price
Rp 21.000.000
Sale price
Rp 24.000.000
Onemed Oneheart AED B8 HeartSave Full Auto w/ Screen & CPR
Regular price
Rp 25.900.000
Sale price
Rp 29.000.000
Onemed Oneheart AED B8 HeartSave Full Auto w/ Screen
Regular price
Rp 24.800.000
Sale price
Rp 28.000.000
Nesco Effect 2500VF Anti-decubitus Mattress
Regular price
Rp 445.000
Sale price
Rp 850.000
Elvasense BP310 Blood Pressure Monitor
Regular price
Rp 359.000
Sale price
Rp 590.000
Healthcare HC-AM01 Anti-Decubitus Air Mattress with Pump
Regular price
Rp 450.000
Sale price
Rp 499.000
Onemed Transfer Pipette 5ml 5cc /1
Regular price
Rp 7.500
Onemed Transfer Pipette 1ml 1cc /1
Regular price
Rp 5.900
Onemed Petridish Glass
Regular price
Rp 11.500
Sale price
Rp 18.000
GEA ADM 300B Anti Decubitus Mattress System Blue
Regular price
Rp 1.370.000
Sale price
Rp 1.900.000
Onehealth OH-500H Pulse Oximeter For Children
Regular price
Rp 245.000
Sale price
Rp 285.000